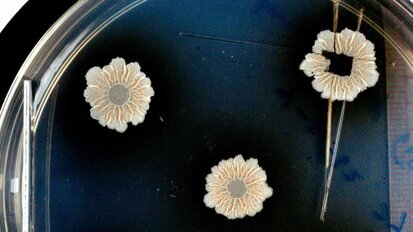
Strukturen des Biofilms und deren Auswirkungen entschlüsselt Strukturen des Biofilms und deren Auswirkungen entschlüsselt

-
 Österreich / Österreich
Österreich / Österreich
-
 Bosnien und Herzegowina / Босна и Херцеговина
Bosnien und Herzegowina / Босна и Херцеговина
-
 Bulgarien / България
Bulgarien / България
-
 Kroatien / Hrvatska
Kroatien / Hrvatska
-
 Tschechien & Slowakei / Česká republika & Slovensko
Tschechien & Slowakei / Česká republika & Slovensko
-
 Frankreich / France
Frankreich / France
-
 Deutschland / Deutschland
Deutschland / Deutschland
-
 Griechenland / ΕΛΛΑΔΑ
Griechenland / ΕΛΛΑΔΑ
-
 Ungarn / Hungary
Ungarn / Hungary
-
 Italien / Italia
Italien / Italia
-
 Niederlande / Nederland
Niederlande / Nederland
-
 Nordic / Nordic
Nordic / Nordic
-
 Polen / Polska
Polen / Polska
-
 Portugal / Portugal
Portugal / Portugal
-
 Rumänien & Moldawien / România & Moldova
Rumänien & Moldawien / România & Moldova
-
 Slowenien / Slovenija
Slowenien / Slovenija
-
 Serbien & Montenegro / Србија и Црна Гора
Serbien & Montenegro / Србија и Црна Гора
-
 Spanien / España
Spanien / España
-
 Schweiz / Schweiz
Schweiz / Schweiz
-
 Türkei / Türkiye
Türkei / Türkiye
-
 Großbritannien und Irland / UK & Ireland
Großbritannien und Irland / UK & Ireland
 International / International
International / International
 Brasilien / Brasil
Brasilien / Brasil
 Kanada / Canada
Kanada / Canada
 Lateinamerika / Latinoamérica
Lateinamerika / Latinoamérica
 USA / USA
USA / USA
 China / 中国
China / 中国
 Indien / भारत गणराज्य
Indien / भारत गणराज्य
 Pakistan / Pākistān
Pakistan / Pākistān
 Vietnam / Việt Nam
Vietnam / Việt Nam
 ASEAN / ASEAN
ASEAN / ASEAN
 Israel / מְדִינַת יִשְׂרָאֵל
Israel / מְדִינַת יִשְׂרָאֵל
 Algerien, Marokko und Tunesien / الجزائر والمغرب وتونس
Algerien, Marokko und Tunesien / الجزائر والمغرب وتونس
 Naher Osten / Middle East
Naher Osten / Middle East